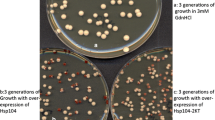

Abstract
The yeast prions (infectious proteins) [URE3] and [PSI+] are essentially non-functional (or even toxic) amyloid forms of Ure2p and Sup35p, whose normal function is in nitrogen catabolite repression and translation termination, respectively. Yeast has an array of systems working in normal cells that largely block infection with prions, block most prion formation, cure most nascent prions and mitigate the toxic effects of those prions that escape the first three types of systems. Here we review recent progress in defining these anti-prion systems, how they work and how they are regulated. Polymorphisms of the prion domains partially block infection with prions. Ribosome-associated chaperones ensure proper folding of nascent proteins, thus reducing [PSI+] prion formation and curing many [PSI+] variants that do form. Btn2p is a sequestering protein which gathers [URE3] amyloid filaments to one place in the cells so that the prion is often lost by progeny cells. Proteasome impairment produces massive overexpression of Btn2p and paralog Cur1p, resulting in [URE3] curing. Inversely, increased proteasome activity, by derepression of proteasome component gene transcription or by 60S ribosomal subunit gene mutation, prevents prion curing by Btn2p or Cur1p. The nonsense-mediated decay proteins (Upf1,2,3) cure many nascent [PSI+] variants by associating with Sup35p directly. Normal levels of the disaggregating chaperone Hsp104 can also cure many [PSI+] prion variants. By keeping the cellular levels of certain inositol polyphosphates / pyrophosphates low, Siw14p cures certain [PSI+] variants. It is hoped that exploration of the yeast innate immunity to prions will lead to discovery of similar systems in humans.

Modified from ref. (Wickner et al. 2015). All figures were produced using CorelDraw



Similar content being viewed by others
Availability of data and material
Not applicable.
Code availability
Not applicable.
References
Albanese V, Reissmann S, Frydman J (2010) A ribosome-anchored chaperone network that facilitates eukaryotic ribosome biogenesis. J Cell Biol 189:69–81
Alper T, Haig DA, Clarke MC (1966) The exceptionally small size of the scrapie agent. Biochem Biophys Res Commun 22:278–284
Amor AJ, Castanzo DT, Delany SP, Selechnik DM, van Ooy A, Cameron DM (2015) The ribosome-associated complex antagonizes prion formation in yeast. Prion 9:144–164
Barbitoff YA, Matveenko AG, Moskalnko SE, Zemlyanko OM, Newnam GP, Patel A, Chernova TA, Chernoff YO, Zhouravleva GA (2017) To CURe or not to CURe? Differential effects of the chaperone sorting factor Cur1 on yeast prions are mediated by the chaperone Sis1. Mol Microbiol 105:242–257
Bateman DA, Wickner RB (2012) [PSI+] prion transmission barriers protect Saccharomyces cerevisiae from infection: intraspecies ‘species barriers.’ Genetics 190:569–579
Bateman D, Wickner RB (2013) The [PSI+] prion exists as a dynamic cloud of variants. Plos Genet 9:e1003257
Baudin-Baillieu A, Fernandez-Bellot E, Reine F, Coissac E, Cullin C (2003) Conservation of the prion properties of Ure2p through evolution. Mol Biol Cell 14:3449–3458
Baxa U, Taylor KL, Wall JS, Simon MN, Cheng N, Wickner RB, Steven A (2003) Architecture of Ure2p prion filaments: the N-terminal domain forms a central core fiber. J Biol Chem 278:43717–43727
Baxa U, Wickner RB, Steven AC, Anderson D, Marekov L, Yau W-M, Tycko R (2007) Characterization of β-sheet structure in Ure2p1-89 yeast prion fibrils by solid state nuclear magnetic resonance. Biochemistry 46:13149–13162
Bergstrom CT, Lipsitch M, Levin BR (2000) Natural selection, infectious transfer and the existence conditions for bacterial plasmids. Genetics 155:1505–1519
Bezsonov EE, Edskes HE, Wickner RB (2021) Innate immunity to yeast prions: Btn2p and Cur1p curing of the [URE3] prion is prevented by 60S ribosomal protein deficiency or ubiquitin/proteasome system overactivity. Genetics 217(4):iyab013. https://doi.org/10.1093/genetics/iyab013
Bolton DC, McKinley MP, Prusiner SB (1982) Identification of a protein that purifies with the scrapie prion. Science 218:1309–1311
Brachmann A, Baxa U, Wickner RB (2005) Prion generation in vitro: amyloid of Ure2p is infectious. Embo J 24:3082–3092
Chakravarty AK, Smejkal T, Itakura AK, Garcia DM, Jarosz DF (2020) A non-amyloid prion particle that activates a heritable gene expression program. Mol Cell 77:251–265
Chan JCC, Oyler NA, Yau W-M, Tycko R (2005) Parallel β-sheets and polar zippers in amyloid fibrils formed by residues 10–39 of the yeast prion protein Ure2p. Biochemistry 44:10669–10680
Chen B, Newnam GP, Chernoff YO (2007) Prion species barrier between the closely related yeast proteins is detected despite coaggregation. Proc Natl Acad Sci USA 104:2791–2796
Chen B, Thurber KR, Shewmaker F, Wickner RB, Tycko R (2009) Measurement of amyloid fibril mass-per-length by tilted-beam transmission electron microscopy. Proc Natl Acad Sci USA 106:14339–14344
Cheng Z, Mugler CF, Keskin A, Hodapp S, Chan LY-L, Weis K, Mertins P, Regev A, Jovanovic M, Brar GA (2019) Small and large ribosomal subunit deficiencies lead to distinct gene expression signatures that reflect cellular growth rate. Mol Cell 73:36–47
Chernoff YO, Kiktev DA (2016) Dual role of ribosome-associated chaperones in prion formation and propagation. Curr Genet 62:677–685
Chernoff YO, Lindquist SL, Ono B-I, Inge-Vechtomov SG, Liebman SW (1995) Role of the chaperone protein Hsp104 in propagation of the yeast prion-like factor [psi+]. Science 268:880–884
Chernoff YO, Newnam GP, Kumar J, Allen K, Zink AD (1999) Evidence for a protein mutator in yeast: role of the Hsp70-related chaperone Ssb in formation, stability and toxicity of the [PSI+] prion. Mol Cell Biol 19:8103–8112
Chernoff YO, Galkin AP, Lewitin E, Chernova TA, Newnam GP, Belenkiy SM (2000) Evolutionary conservation of prion-forming abilities of the yeast Sup35 protein. Molec Microbiol 35:865–876
Collins SR, Douglass A, Vale RD, Weissman JS (2004) Mechanism of prion propagation: amyloid growth occurs by monomer addition. Plos Biol 2:1582–1590
Cooper TG (2002) Transmitting the signal of excess nitrogen in Saccharomyces cerevisiae from the Tor proteins to the GATA factors: connecting the dots. FEMS Microbiol Revs 26:223–238
Cox BS (1965) PSI, a cytoplasmic suppressor of super-suppressor in yeast. Heredity 20:505–521
Cox BS, Tuite MF, McLaughlin CS (1988) The Psi factor of yeast: a problem in inheritance. Yeast 4:159–179
Cox BS, Ness F, Tuite MF (2003) Analysis of the generation and segregation of propagons: entities that propagate the [PSI+] prion in yeast. Genetics 165:23–33
Czaplinski K, Ruiz-Echevarria MJ, Paushkin SV, Han X, Weng Y, Perlick HA, Dietz HC, Ter-Avanesyan MD, Peltz SW (1998) The surveillance complex interacts with the translation release factors to enhance termination and degrade aberrant mRNAs. Genes Dev 12:1665–1677
de Oliveira GAP, Petronilho EC, Pedrote MM, Marques MA, Vieira T, Cino EA, Silva JL (2020) The status of p53 oligomeric and aggregation states in cancer. Biomolecules 10:548
Debets AJ, Dalstra HJ, Slakhorst M, Koopmanschap B, Hoekstra RF, Saupe SJ (2012) High natural prevalence of a fungal prion. Proc Natl Acad Sci USA 109:10432–10437
DePace AH, Santoso A, Hillner P, Weissman JS (1998) A critical role for amino-terminal glutamine/asparagine repeats in the formation and propagation of a yeast prion. Cell 93:1241–1252
Dergalev AA, Alexandrovg A, Ivannikov RI, Ter-Avanesyan MD, Kushnirov VV (2019) Yeast Sup35 prion structure: two types, four parts, many variants. Int J Mol Sci 20:2633. https://doi.org/10.3390/ijms20112633
Derkatch IL, Chernoff YO, Kushnirov VV, Inge-Vechtomov SG, Liebman SW (1996) Genesis and variability of [PSI] prion factors in Saccharomyces cerevisiae. Genetics 144:1375–1386
Derkatch IL, Bradley ME, Zhou P, Chernoff YO, Liebman SW (1997) Genetic and environmental factors affecting the de novo appearance of the [PSI+] prion in Saccharomyces cerevisiae. Genetics 147:507–519
Derkatch IL, Bradley ME, Hong JY, Liebman SW (2001) Prions affect the appearance of other prions: the story of [PIN]. Cell 106:171–182
Diaz-Avalos R, King CY, Wall JS, Simon M, Caspar DLD (2005) Strain-specific morphologies of yeast prion amyloids. Proc Natl Acad Sci USA 102:10165–10170
Diringer H, Gelderblom H, Hilmert H, Ozel M, Edelbluth C, Kimberlin RH (1983) Scrapie infectivity, fibrils and low molecular weight protein. Nature 306:476–478
Doel SM, McCready SJ, Nierras CR, Cox BS (1994) The dominant PNM2- mutation which eliminates the [PSI] factor of Saccharomyces cerevisiae is the result of a missense mutation in the SUP35 gene. Genetics 137:659–670
Dorweiler JE, Obaoye JO, Oddo MJ, Shilati FM, Scheidemantle GM, Coleman TJ, Reilly JA, Smith GR, Manogaran AL (2020) DMSO-mediated curing of several yeast prion variants involves Hsp104 expression and protein solubilization, and is decreased in several autophagy related (atg) mutants. PLoS ONE 15:e0229796
Edmunds DR, Kauffman MJ, Schumaker BA, Lindzey FG, Cook WE, Kreeger TJ, Grogan RG, Cornish TE (2016) Chronic wasting disease drives population decline white-tailed deer. PLoS ONE 11:e0161127
Edskes HK, Wickner RB (2002) Conservation of a portion of the S cerevisiae Ure2p prion domain that interacts with the full—length protein. Proc Natl Acad Sci USA 99(Suppl. 4):16384–16391
Edskes HK, Gray VT, Wickner RB (1999) The [URE3] prion is an aggregated form of Ure2p that can be cured by overexpression of Ure2p fragments. Proc Natl Acad Sci USA 96:1498–1503
Edskes HE, Mukhamedova M, Edskes BK, Wickner RB (2018) Hermes transposon mutagenesis shows [URE3] prion pathology prevented by a ubiquitin-targeting protein: evidence for carbon/nitrogen assimilation cross-talk and a second function for Ure2p. Genetics 209:789–800
Edskes HE, Stroobant EE, DeWilde M, Bezsonov EE, Wickner RB (2021) Proteasome control of [URE3] prion propagation by degradation of anti-prion proteins Cur1 and Btn2 in Saccharomyces cerevisiae. Genetics 218(1):iyab037. https://doi.org/10.1093/genetics/iyab037
Futcher AB, Cox BS (1983) Maintenance of the 2 μm circle plasmid in populations of Saccharomyces cerevisiae. J Bacteriol 154:612–622
Futcher B, Reid E, Hickey DA (1988) Maintenance of the 2 micron circle plasmid of Saccharomyces cerevisiae by sexual transmission: an example of selfish DNA. Genetics 118:411–415
Gallina I, Colding C, Henriksen P, Beli P, Nakamura K, Offman J, Mathiasen DP, Silva S, Hoffmann E, Groth A, Choudhary C, Lisby M (2015) Cmr1/WDR76 defines a nuclear genotoxic stress body linking genome integrity and protein quality control. Nat Commun 6:6533
Gartenberg MR, Smith JS (2016) The nuts and bolts of transcriptionally silent chromatin in Saccharomyces cerevisiae. Genetics 203:1563–1599
Gasch AP, Spellman PT, Kao CM, Carmel-Harel O, Eisen MB, Storz G, Botstein D, Brown PO (2000) Genomic expression programs in the response of yeast cells to environmental changes. Mol Biol Cell 11:4241–4257
Glover JR, Lindquist S (1998) Hsp104, Hsp70, and Hsp40: a novel chaperone system that rescues previously aggregated proteins. Cell 94:73–82
Glover JR, Kowal AS, Shirmer EC, Patino MM, Liu J-J, Lindquist S (1997) Self-seeded fibers formed by Sup35, the protein determinant of [PSI+], a heritable prion-like factor of S. cerevisiae. Cell 89:811–819
Gorkovskiy A, Thurber KR, Tycko R, Wickner RB (2014) Locating folds of the in-register parallel β-sheet of the Sup35p prion domain infectious amyloid. Proc Natl Acad Sci USA 111:E4615–E4622
Gorkovskiy A, Reidy M, Masison DC, Wickner RB (2017) Hsp104 at normal levels cures many [PSI+] variants in a process promoted by Sti1p, Hsp90 and Sis1p. Proc Natl Acad Sci USA 114:E4193–E4202
Griffith JS (1967) Self-replication and scrapie. Nature 215:1043–1044
Hallstrom TC, Katzmann DJ, Torres RJ, Sharp WJ, Moye-Rowley WS (1998) Regulation of transcription factor Pdr1p function by an Hsp70 protein in Saccharomyces cerevisiae. Mol Cell Biol 18:1147–1155
Harper DC, Theos AC, Herman KE, Tenza D, Raposo G, Marks MS (2008) Premelanosome amyloid-like fibrils are composed of only Golgi-processed forms of Pmel17 that have been proteolytically processed in endosomes. J Biol Chem 283:2307–2322
Harris JM, Nguyen PP, Patel MJ, Sporn ZA, Hines JK (2014) Functional diversification of Hsp40: distinct J-protein functional requirements for two prions allow for chaperone-dependent prion selection. PLOS Genet 10:e41004510
He F, Jacobson A (2015) Nonsense-mediated mRNA decay: degradation of defective transcripts is only part of the story. Ann Rev Genet 49:339–366
Helsen CW, Glover JR (2012) Insight into molecular basis of curing of [PSI+] prion by overexpression of 104-kDa heat shock protein (Hsp104). J Biol Chem 287:542–556
Higurashi T, Hines JK, Sahi C, Aron R, Craig EA (2008) Specificity of the J-protein Sis1 in the propagation of 3 yeast prions. Proc Natl Acad Sci USA 105:16596–16601
Hosoda N, Kobayashii T, Uchida N, Funakoshi Y, Kikuchi Y, Hoshino S, Katada T (2003) Translation termination factor eRF3 mediates mRNA decay through the regulation of deadenylation. J Biol Chem 278:38287–38291
Hua Z, Vierstra RD (2011) The cullin-ring ubiquitin-protein ligases. Ann Rev Plant Path 62:299–334
Huang Y-W, Kushnirov NV, King C-Y (2021) Mutable yeast prion variants are stabilized by a defective Hsp104 chaperone. Mol Microbiol 115(4):774–788. https://doi.org/10.1111/mmi.14643
Hung GC, Masison DC (2006) N-terminal domain of yeast Hsp104 chaperone is dispensable for thermotolerance and prion propagation but necessary for curing prions by Hsp104 overexpression. Genetics 173:611–620
Iconomidou VA, Hamodrakas SJ (2008) Natural protective amyloids. Curr Protein Pept Sci 9:291–309
Jain N, Chapman MR (2019) Bacterial functional amyloids: order from disorder. Biochim Biophys Acta Proteins Proteom 1867:954–960
Jaunmuktane Z, Mead S, Ellis M, Wadsworth JD, Nicoll AJ, Kenny J, Launchbury F, Linehan J, Richard-Loendt A, Walker AS, Rudge P, Collinge J, Brandner S (2015) Evidence for human transmission of amyloid-β pathology and cerebral amyloid angiopathy. Nature 525:247–250
Johnston JA, Ward CL, Kopito RR (1999) Aggresomes: a cellular response to misfolded proteins. J Cell Biol 143:1883–1898
Jonkers W, Rep M (2009) Lessons from fungal F-box proteins. Eukaryot Cell 8:677–695
Kama R, Robinson M, Gerst JE (2007) Btn2, a Hook1 ortholog and potential Batten disease-related protein, mediates late endosome-Golgi protein sorting in yeast. Mol Cell Biol 27:605–621
Kanneganti V, Kama R, Gerst JE (2011) Btn3 is a negative regulator of Btn2-mediated endosomal protein trafficking and prion curing in yeast. Mol Biol Cell 22:1648–1663
Kelly AC, Shewmaker FP, Kryndushkin D, Wickner RB (2012) Sex, prions and plasmids in yeast. Proc Natl Acad Sci USA 109:E2683–E2690
Kiktev DA, Melomed MM, Lu CD, Newnam GP, Chernoff YO (2015) Feedback control of prion formation and propagation by the ribosome-associated chaperone complex. Mol Microbiol 96:621–632
Kim S, Kwon S-H, Kam T-I, Panicker N, Karuppagounder SS, Lee S, Lee JH, Kim WR, Kook M, Foss CA, Shen C, Lee H, Kulkami S, Pasricha PJ, Lee G, Pomper MG, Dawson VL, Dawson TM, Ko HS (2019) Transneuronal propagation of pathologic α-synuclein from the gut to the brain models Parkinson’s disease. Neuron 103:627–641
King CY (2001) Supporting the structural basis of prion strains: induction and identification of [PSI] variants. J Mol Biol 307:1247–1260
King C-Y, Diaz-Avalos R (2004) Protein-only transmission of three yeast prion strains. Nature 428:319–323
King C-Y, Tittmann P, Gross H, Gebert R, Aebi M, Wuthrich K (1997) Prion-inducing domain 2–114 of yeast Sup35 protein transforms in vitro into amyloid-like filaments. Proc Natl Acad Sci USA 94:6618–6622
Kirkland PA, Reidy M, Masison DC (2011) Functions of yeast Hsp40 chaperone Sis1p dispensable for prion propagation but important for prion curing and protection from prion toxicity. Genetics 188:565–577
Koplin A, Preissler S, Ilina Y, Kock M, Scior A, Erhardt M, Deuerling E (2010) A dual function for chaperones SSB-RAC and the NAC nascent polypeptide-associated complex on ribosomes. J Cell Biol 189:57–68
Kryndushkin D, Wickner RB (2007) Nucleotide exchange factors for Hsp70s are required for [URE3] prion propagation in Saccharomyces cerevisiae. Mol Biol Cell 18:2149–2154
Kryndushkin D, Shewmaker F, Wickner RB (2008) Curing of the [URE3] prion by Btn2p, a Batten disease-related protein. EMBO J 27:2725–2735
Kryndushkin D, Ihrke G, Piermartiri TC, Shewmaker F (2012) A yeast model of optineurin proteinopathy reveals a unique aggregation pattern associated with cellular toxicity. Mol Microbiol 86:1531–1547
Kumar J, Masison DC (2021) Yeast J-protein Sis1 prevents prion toxicity by maintaining prion protein solubility. Genetics Submitted
Kumar N, Gaur D, Gupta A, Puri A, Sharma D (2015) Hsp90-associated immunophilin homolog Cpr7 is required for the mitotic stability of [URE3] prion in Saccharomyces cerevisiae. PLOS Genet 11:e1005567
Kumar S, Dine EA, Paddock E, Steinberg DN, Greene LE, Masison DC (2020) Mutations outside the Ure2 amyloid-forming region disrupt [URE3] prion propagation and alter interactions with protein quality control factors. Mol Cell Biol 40:e00294–20
Kushnirov VV, Kochneva-Pervukhova NV, Cechenova MB, Frolova NS, Ter-Avanesyan MD (2000a) Prion properties of the Sup35 protein of yeast Pichia methanolica. EMBO J 19:324–331
Kushnirov VV, Kryndushkin DS, Boguta M, Smirnov VN, Ter-Avanesyan MD (2000b) Chaperones that cure yeast artificial [PSI+] and their prion-specific effects. Curr Biol 10:1443–1446
Lacroute F (1971) Non-Mendelian mutation allowing ureidosuccinic acid uptake in yeast. J Bacteriol 106:519–522
Li X, Kandel ER, Derkatch IL (2014) Functional role of Tia1/Pub1 and Sup35 prion domains: directing protein synthesis machinery to the tubulin cytoskeleton. Mol Cell 55:305–318
Luke MM, Sutton A, Arndt KT (1991) Characterization of SIS1, a Saccharomyces cerevisiae homolog of bacterial dnaJ proteins. J Cell Biol 114:623–638
Lum R, Tkach JM, Vierling E, Glover JR (2004) Evidence for an unfolding/threading mechanism for protein disaggregation by Saccharomyces cerevisiae Hsp104. J Biol Chem 279:29139–29146
Lum R, Niggemann M, Glover JR (2008) Peptide and protein binding in the axial channel of Hsp104. Insights into the mechanism of protein unfolding. J Biol Chem 283:30139–30146
Mackay JP, Matthews JM, Winefield RD, Mackay LG, Haverkamp RG, Templeton MD (2001) The hydrophobin EAS is largely unstructured in solution and functions by forming amyloid-like structures. Struct (camb) 9:83–91
Maffucci T, Falasca M (2020) Signalling properties of inositol polyphosphates. Molecules 25:5281. https://doi.org/10.3390/molecules25225281
Maldonado-Baez L, Cole NB, Kramer H, Donaldson JG (2013) Microtubule-dependent endosomal sorting of clathrin-independent cargo by Hook1. J Cell Biol 201:233–247
Malinovska L, Kroschwald S, Munder MC, Richter D, Alberti S (2012) Molecular chaperones and stress-inducible protein-sorting factors coordinate the spaciotemporal distribution of protein aggregates. Mol Biol Cell 23:3041–3056
Masel J, Griswold CK (2009) The strength of selection against the yeast prion [PSI+]. Genetics 181:1057–1063
Masison DC, Wickner RB (1995) Prion-inducing domain of yeast Ure2p and protease resistance of Ure2p in prion-containing cells. Science 270:93–95
Masison DC, Maddelein M-L, Wickner RB (1997) The prion model for [URE3] of yeast: spontaneous generation and requirements for propagation. Proc Natl Acad Sci USA 94:12503–12508
McGlinchey R, Kryndushkin D, Wickner RB (2011) Suicidal [PSI+] is a lethal yeast prion. Proc Natl Acad Sci USA 108:5337–5341
Mead DJ, Gardner DCJ, Oliver SG (1986) The yeast 2 μ plasmid: strategies for the survival of a selfish DNA. Mol Gen Genet 205:417–421
Mead S, Stumpf MP, Whitfield J, Beck JA, Poulter M, Campbell T, Uphill JB, Goldstein D, Alpers M, Fisher EM, Collinge J (2003) Balancing selection at the prion protein gene consistent with prehistoric kurulike epidemics. Science 300:640–643
Miller SB, Ho CT, Winkler J, Khokhrina M, Neuner A, Mohamed MY, Guilbride DL, Richter K, Lisby M, Scheibel E, Mogk A, Bukau B (2015) Compartment-specific aggregases direct distinct nuclear and cytoplasmic aggregate deposition. EMBO J 34:778–797
Moosavi B, Wongwigkam J, Tuite MF (2010) Hsp70/Hsp90 co-chaperones are required for efficient Hsp104-mediated elimination of the yeast [PSI+] prion but not for prion propagation. Yeast 27:167–179
Moriyama H, Edskes HK, Wickner RB (2000) [URE3] prion propagation in Saccharomyces cerevisiae: requirement for chaperone Hsp104 and curing by overexpressed chaperone Ydj1p. Mol Cell Biol 20:8916–8922
Morrissette VA, Rolfes RJ (2020) The intersection between stress responses and inositol pyrophosphates in Saccharomyces cerevisiae. Curr Genet 66:901–910
Mukherjee A, Morales-Scheihing D, Salvadores N, Moreno-Gonzales I, Gonzales C, Taylor-Presse K, Mendez N, Shahnawaz M, Gaber AO, Sabek OM, Fraga DW, Soto C (2017) Induction of IAPP amyloid deposition and associated diabetic abnormalities by a prion-like mechanism. J Exper Med 214:2591–2610
Nakayashiki T, Kurtzman CP, Edskes HK, Wickner RB (2005) Yeast prions [URE3] and [PSI+] are diseases. Proc Natl Acad Sci USA 102:10575–10580
Navalkar A, Ghosh S, Pandey S, Paul A, Datta D, Maji SK (2020) Prion-like p53 amyloids in cancer. Biochemistry 59:146–155
Nelson RJ, Ziegilhoffer T, Nicolet C, Werner-Washburne M, Craig EA (1992) The translation machinery and 70 kDal heat shock protein cooperate in protein synthesis. Cell 71:97–105
Ness F, Cox B, Wonwigkam J, Naeimi WR, Tuite MF (2017) Over-expression of the molecular chaperone Hsp104 in Saccharomyces cerevisiae results in the malpartition of [PSI+] propagons. Mol Microbiol 104:125–143
Newnam GP, Birchmore JL, Chernoff YO (2011) Destabilization and recovery of a yeast prion after mild heat shock. J Mol Biol 408:432–448
Ngo S, Gu L, Guo Z (2011) Hierarchical organization in the amyloid core of yeast prion protein Ure2. J Biol Chem 286:29691–29699
Ngo S, Chiang V, Guo Z (2012) Quantitative analysis of spin exchange interactions to identify β strand and turn regions in Ure2 prion domain fibrils with site-directed spin labeling. J Struct Biol 180:374–381
Ohhashi Y, Yamaguchi Y, Kurahashi H, Kamatari YO, Sugiyama S, Uluca B, Piechatzek T, Komi Y, Shida T, Muller H, Hanashima S, Heise H, Kuwata K, M. T, (2018) Molecular basis for diversification of yeast prion strain conformation. Proc Natl Acad Sci USA 115:2389–2394
Oliver EE, Troisi EM, Hines JK (2017) Prion-specific Hsp40 function: the role of the auxilin homolog Swa2. Prion 11:174–185
Park YN, Zhou X, Yim YI, Todor H, Ellerbrock R, Reidy M, Eisenberg E, Masison DC, Greene LE (2014) Hsp104 overexpression cures Saccharomyces cerevisiae [PSI+] by causing dissolution of the prion seeds. Eukaryot Cell 13:635–647
Park Y, Park J, Hwang HJ, Kim B, Kwon J, ChangLeeKim JJ-BYK (2018) Nonsense-mediated mRNA decay factor UPF1 promotes aggresome formation. Nat Comm 11:3106. https://doi.org/10.1038/s41467-020-16939-6
Park S-K, Park S, Pentek C, Liebman SW (2021) Tumor suppressor protein p53 expressed in yeast can remain diffuse, form a prion, or form unstable liquid-like droplets. Science 24:102000
Paushkin SV, Kushnirov VV, Smirnov VN, Ter-Avanesyan MD (1996) Propagation of the yeast prion-like [psi+] determinant is mediated by oligomerization of the SUP35-encoded polypeptide chain release factor. EMBO J 15:3127–3134
Podrabsky JE, Carpenter JF, Hand SC (2001) Survival of water stress in annual fish embryos: dehydration avoidance and egg amyloid fibers. Am J Physiol Regul Integr Comp Physiol 280:R123–R131
Prusiner SB (1982) Novel proteinaceous infectious particles cause scrapie. Science 216:136–144
Prusiner SB, Scott M, Foster D, Pan K-M, Groth D, Mirenda C, Torchia M, Yang S-L, Serban D, Carlson GA, Hoppe PC, Westaway D, DeArmond SJ (1990) Transgenic studies implicate interactions between homologous PrP isoforms in scrapie prion replication. Cell 63:673–686
Puri A, Singh P, Kumar N, Kumar R, Sharma D (2021) Tah1, a key component of R2TP complex that regulates assembly of snoRNP, is involved in de novo generation and maintenance of yeast prion [URE3]. J Mol Biol. https://doi.org/10.1016/j.jmb.2021.166976 (Online ahead of print)
Reidy M, Masison DC (2010) Sti1 regulation of Hsp70 and Hsp90 is critical for curing of Saccharomyces cerevisiae [PSI+] prions by Hsp104. Mol Cell Biol 30:3542–3552
Reidy M, Kumar S, Anderson DE, Masison DC (2018) Dual roles for yeast Sti1/Hop in regulating the Hsp90 chaperone cycle. Genetics 209:1139–1154
Resende CG, Outeiro TF, Sands L, Lindquist S, Tuite MF (2003) Prion protein gene polymorphisms in Saccharomyces cerevisiae. Mol Microbiol 49:1005–1017
Roberts BT, Moriyama H, Wickner RB (2004) [URE3] prion propagation is abolished by a mutation of the primary cytosolic Hsp70 of budding yeast. Yeast 21:107–117
Sampson TR, Challis C, Jain N, Moiseyenko A, Ladinsky MS, Shastri GG, Thron T, Needham BD, Horvath I, Debelius JW, Janssen S, Knight R (2020) A gut bacterial amyloid promotes α-synuclein aggregation and motor impairment in mice. Elife 9:e53111
Santoso A, Chien P, Osherovich LZ, Weissman JS (2000) Molecular basis of a yeast prion species barrier. Cell 100:277–288
Sarikas A, Hartmann T, Pan ZQ (2011) The cullin protein family. Genome Biol. https://doi.org/10.1186/gb-2011-1112-1184-1220
Saupe SJ (2011) The [Het-s] prion of Podospora anserina and its role in heterokaryon incompatibility. Sem Cell Dev Biol 22:460–468
Schlieker C, Tews I, Bukau B, Mogk A (2004) Solubilization of aggregated proteins by ClpB/DnaK relies on the continuous extraction of unfolded polypeptides. FEBS Lett 578:351–356
Seol JH, Shevchenko A, Shevchenko A, Deshales RJ (2001) Skip1 forms multiple protein complexes, including RAVE, a regulator of V-ATPase assembly. Nat Cell Biol 3:384–391
Sharma D, Masison DC (2008) Functionally redundant isoforms of a yeast Hsp70 chaperone subfamily have different antiprion effects. Genetics 179:1301–1311
Shewmaker F, Wickner RB, Tycko R (2006) Amyloid of the prion domain of Sup35p has an in-register parallel β-sheet structure. Proc Natl Acad Sci USA 103:19754–19759
Shewmaker F, Mull L, Nakayashiki T, Masison DC, Wickner RB (2007) Ure2p function is enhanced by its prion domain in Saccharomyces cerevisiae. Genetics 176:1557–1565
Son M, Wickner RB (2018) Nonsense-mediated mRNA decay factors cure most [PSI+] prion variants. Proc Natl Acad Sci USA 115:1184–1193 (pii: 201717495. doi: 201717410.201711073/pnas.1717495115)
Son M, Wickner RB (2020) Normal levels of ribosome-associated chaperones cure two groups of [PSI+] variants. Proc Natl Acad Sci USA 117:26298–26306. https://doi.org/10.1073/pnas.2016954117
Sondheimer N, Lindquist S (2000) Rnq1: An epigenetic modifier of protein function in yeast. Mol Cell 5:163–172
Specht S, Miller SBM, Mogk A, Bukau B (2011) Hsp42 is required for sequestration of protein aggregates into deposition sites in Saccharomyces cerevisiae. J Cell Biol 195:617–629
Speldewinde SH, Grant CM (2016) Spermidine cures yeast of prions. Microbial Cell 3:46–48
Speldewinde SH, Grant CM (2017) The frequency of yeast [PSI+] prion formation is increased during chronological aging. Microbial Cell 4:127–132
Steidle EA, Chong LS, Wu M, Crooke E, Fiedler D, Resnick AC, Rolfes RJ (2016) A novel inositol pyrophosphate phosphatase in Saccharomyces cerevisiae: Siw14 protein selectively cleaves the β-phosphate from 5-diphosphoinositol pentakisphosphate (5PP-IP5). J Biol Chem 291:6772–6783
Stewart FM, Levin BR (1977) The population biology of bacterial plasmids: a priori conditions for the existence of conjugationally transmitted factors. Genetics 87:209–228
Tanaka M, Chien P, Naber N, Cooke R, Weissman JS (2004) Conformational variations in an infectious protein determine prion strain differences. Nature 428:323–328
Tanaka M, Collins SR, Toyama BH, Weissman JS (2006) The physical basis of how prion conformations determine strain phenotypes. Nature 442:585–589
Taylor KL, Cheng N, Williams RW, Steven AC, Wickner RB (1999) Prion domain initiation of amyloid formation in vitro from native Ure2p. Science 283:1339–1343
Ter-Avanesyan MD, Dagkesamanskaya AR, Kushnirov VV, Smirnov VN (1994) The SUP35 omnipotent suppressor gene is involved in the maintenance of the non-Mendelian determinant [psi+] in the yeast Saccharomyces cerevisiae. Genetics 137:671–676
Tessarz P, Mogk A, Bukau B (2008) Substrate threading through the central pore of the Hsp104 chaperone as a common mechanism for protein disaggregation and prion propagation. Mol Microbiol 68:87–97
Troisi EM, Rockman ME, Nguyen PP, Oliver EE, Hines JK (2015) Swa2, the yeast homolog of mammalian auxilin, is specifically required for the propagation of the prion variant [URE3-1]. Mol Microbiol 97:926–941
Tycko R (2014) Physical and structural basis for polymorphism in amyloid fibrils. Protein Sci 23:1528–1539
Tycko R, Wickner RB (2013) Molecular structures of amyloid and prion fibrils: consensus vs. controversy. Accounts of Chem Res 46:1487–1496
von Plehwe U, Berndt U, Conz C, Chiabudini M, Fitzke E, Sickmann A, Petersen A, Pfeifer D, Rospert S (2009) The Hsp70 homolog Ssb is essential for glucose sensing via the SNF1 kinase network. Genes Dev 23:2102–2115
Vorberg IM (2019) All the same? The secret life of prion strains within their target cells. Viruses. https://doi.org/10.3390/v11040334
Wang W, Czaplinski K, Rao Y, Peltz SW (2001) The role of Upf proteins in modulating the translation read-through of nonsense-containing transcripts. EMBO J 20:880–890
Wang L, Mao X, Ju D, Xie Y (2004) Rpn4 is a physiological substrate of the Ubr2 ubiquitin ligase. J Biol Chem 279:55218–55223
Wang J, Park G, Lee YK, Nguyen M, San Fung T, Lin TY, Hsu F, Guo Z (2020) Spin label scanning reveals likely locations of beta-strands of the Ure2 prion domain. ACS Omega 5:5984–5993
Wickner RB (1994) [URE3] as an altered URE2 protein: evidence for a prion analog in S. cerevisiae. Science 264:566–569
Wickner RB, Edskes HK, Shewmaker F, Nakayashiki T (2007) Prions of fungi: inherited structures and biological roles. Nat Rev Microbiol 5:611–618
Wickner RB, Dyda F, Tycko R (2008) Amyloid of Rnq1p, the basis of the [PIN+] prion, has a parallel in-register β-sheet structure. Proc Natl Acad Sci USA 105:2403–2408
Wickner RB, Beszonov E, Bateman DA (2014) Normal levels of the antiprion proteins Btn2 and Cur1 cure most newly formed [URE3] prion variants. Proc Natl Aca Sci USA 111:E2711–E2720
Wickner RB, Shewmaker F, Bateman DA, Edskes HE, Gorkovskiy A, Dayani Y, Bezsonov EE (2015) Yeast prions: structure, biology and prion-handling systems. Microbiol Mol Biol Rev 79:1–17
Wickner RB, Kelly AC, Bezsonov EE, Edskes HE (2017) Prion propagation is controlled by inositol polyphosphates. Proc Natl Acad Sci USA 114:E8402–E8410
Wickner RB, Son M, Edskes BK (2019) Prion variants of yeast are numerous, mutable, and segregate on growth, affecting prion pathogenesis, transmission barriers and sensitivity to anti-prioin systems. Viruses. https://doi.org/10.3390/v11030238
Winkler J, Tyedmers J, Bukau B, Mogk A (2012) Hsp70 targets Hsp100 chaperones to substrates for protein disaggregation and prion fragmentation. J Cell Biol 198:387–404
Wolfe KJ, Ren HY, Trepte P, Cyr DM (2013) The Hsp70/90 cochaperone, Sti1, suppresses proteotoxicity by regulating spatial quality control of amyloid-like proteins. Mol Bio Cell 24:3588–3602
Wong S-H, King C-Y (2015) Amino acid proximities in two Sup35 prion strains revealed by chemical cross-linking. J Biol Chem 290:25062–25071
Zhang Y, Sinning I, Rospert S (2017) Two chaperones locked in an embrace: structure and function of the ribosome-associated complex RAC. Nat Struct Biol 24:611–619
Acknowledgements
This work was supported by the Intramural Program of the National Institute of Diabetes and Digestive and Kidney Diseases, National Institutes of Health.
Funding
This work was supported by the Intramural Program of the National Institute of Diabetes and Digestive and Kidney Diseases, National Institutes of Health.
Author information
Authors and Affiliations
Contributions
The first draft of the manuscript was written by RW, and all authors commented on various versions of the manuscript. All authors read and approved the final manuscript.
Corresponding author
Ethics declarations
Conflict of interest
The authors declare no conflicts of interest.
Additional information
Communicated by Michael Polymenis.
Publisher's Note
Springer Nature remains neutral with regard to jurisdictional claims in published maps and institutional affiliations.
Rights and permissions
About this article
Cite this article
Wickner, R.B., Edskes, H.K., Son, M. et al. Innate immunity to prions: anti-prion systems turn a tsunami of prions into a slow drip. Curr Genet 67, 833–847 (2021). https://doi.org/10.1007/s00294-021-01203-1
Received:
Revised:
Accepted:
Published:
Issue Date:
DOI: https://doi.org/10.1007/s00294-021-01203-1